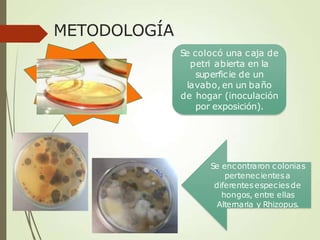
METODOLOGÍA
Se colocó una caja de
petri abierta en la
superficie de un
lavabo, en un baño
de hogar (inoculación
por exposición).
Se encontraron colonias
pertenecientesa
diferentesespeciesde
hongos, entre ellas
Alternaria y Rhizopus.

Este documento presenta información sobre un estudio de micología realizado por estudiantes de la Facultad de Ciencias Químicas de la Universidad Autónoma de San Luis Potosí. El estudio tuvo como objetivos conocer la morfología, métodos de cultivo y tipos de hongos macro y microscópicos. Se incluyen detalles sobre las características de hongos comunes como Rhizopus, Alternaria y casos clínicos de infecciones por estos hongos.